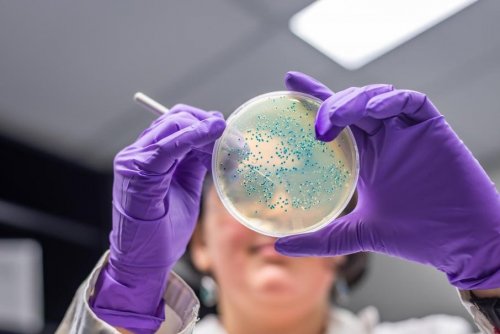

Дубайский шоколад и рак: какая взаимосвязь?
Дубайский шоколад может быть опасен для здоровья: в нем есть потенциально канцерогенные вещества.

Этот напиток защищает от закупорки сосудов, инсульта и инфаркта
Приготовьте напиток из простых продуктов для профилактики инфаркта и инсульта.

Пептид, блокирующий ключевой белок рака, открывает новые перспективы лечения
Учёные разработали пептид, который блокирует важный белок, способствующий росту опухолей, и открывает новые возможности для эффективного лечения рака
Выведены бактерии, которые побеждают рак
Иммунотерапия: бактерии, целенаправленно атакующие раковые клетки.

Специальная техника, которая поможет быстро уснуть
Как быстро уснуть и не просыпаться ночью: техника дыхания 4-7-8.

Сладкие напитки вызывают рак
Ученые обнаружили, что ежедневное употребление сладких напитков может существенно повысить риск рака полости рта.

У каких женщин повышен риск рака груди
Категории женщин с повышенным риском развития рака молочной железы.

Крем L’Oreal может вызывать рак
L’Oreal отзывает крем для лечения акне из-за угрозы онкологии.

Женщина в 57 лет забеременела после 22 лет неудачных попыток
57-летняя жительница Черногории забеременела после 22 лет попыток.

Ученые нашли способ превращать раковые клетки в здоровые
Если открытие подтвердится, то уже через 5-10 лет с его помощью будут лечить все виды рака.

Почему бананы нельзя есть на завтрак
Диетологи пришли к выводу, что бананы натощак не настолько полезны, как мы привыкли думать.

Топ-5 специй, которые защищают от рака
Ученые назвали пять специй с противораковыми свойствами.

Как выявить опасную родинку
Как понять, что родинка перерождается в злокачественную?

Что лучше всего есть на завтрак?
Какой завтрак – самый полезный.

Какие заболевания часто передаются по женской линии
Список болезней, которые могут передаваться в семьях по женской линии.

При каких видах рака шансы на выживаемость самые высокие?
Эти виды рака лечатся наиболее успешно, если выявлены на ранних стадиях.

Продукция Apple вызывает рак
При изготовлении некоторых компонентов айфонов, макбуков и пауэрбанков используется канцероген бисфенол А, запрещенный во многих странах.

Неправильный прием рыбьего жира повышает риски рака груди
Если бесконтрольно принимать рыбий жир, могут появиться серьезные проблемы со здоровьем.

Плотный завтрак продлевает жизнь на 35%
Хотите дольше жить – плотно завтракайте!